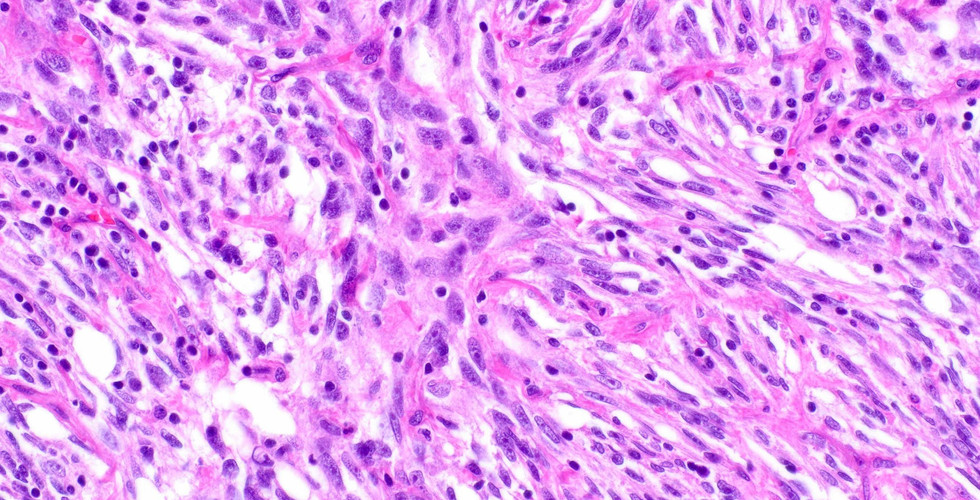

Case
- Elizabeth Montgomery, MD
- 1 hour ago
- 1 min read
This is a beautiful follicular dendritic cell sarcoma that presented as a breast mass. Note the lymphoid cuff and dense tumor infiltrating lymphocytes.
Case by Dr. Elizabeth Montgomery, Clinical Professor, Vice Chair of Faculty Development & Mentoring, Director of Surgical Pathology Fellowship Training Program, Co-Director, Pathology Reference Services, and Editor-In-Chief at Innovative Science Press.
You can check out our titles at:
1-703-350-4308/703-340-3198